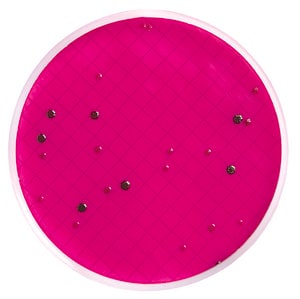
Milliflex agar cassettes (m endo) 1 pack

265746 produits - Trié par pertinence

Réf. UGAP : 3620676 Réf. constructeur : MVN1200

Réf. UGAP : 3615766 Réf. constructeur : ab116028-500uL

Réf. UGAP : 3645316 Réf. constructeur : AM1326

Réf. UGAP : 3666901 Réf. constructeur : 3956301

Réf. UGAP : 3748001 Réf. constructeur : M6752-1L

Réf. UGAP : 3658586 Réf. constructeur : 1202

Réf. UGAP : 3658623 Réf. constructeur : 1093

Réf. UGAP : 3665760 Réf. constructeur : P04-81500

Réf. UGAP : 3658758 Réf. constructeur : 5115
Réf. UGAP : 3735775 Réf. constructeur : MXSMEND48

Réf. UGAP : 3689659 Réf. constructeur : 424802

Réf. UGAP : 3722893 Réf. constructeur : R0637L

Réf. UGAP : 3723681 Réf. constructeur : T2007L

Réf. UGAP : 3857047 Réf. constructeur : 08622701

Réf. UGAP : 3748539 Réf. constructeur : D4551-500ML